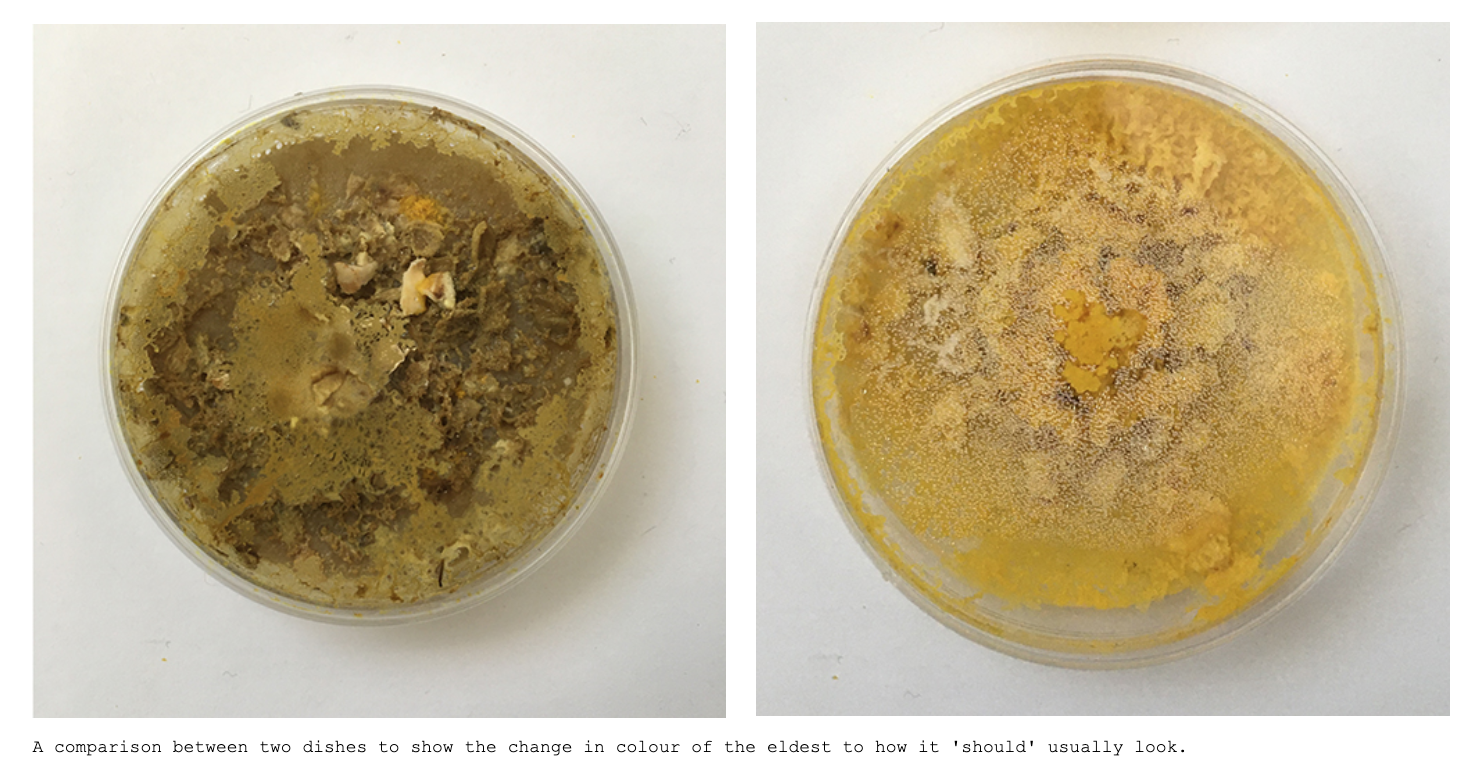
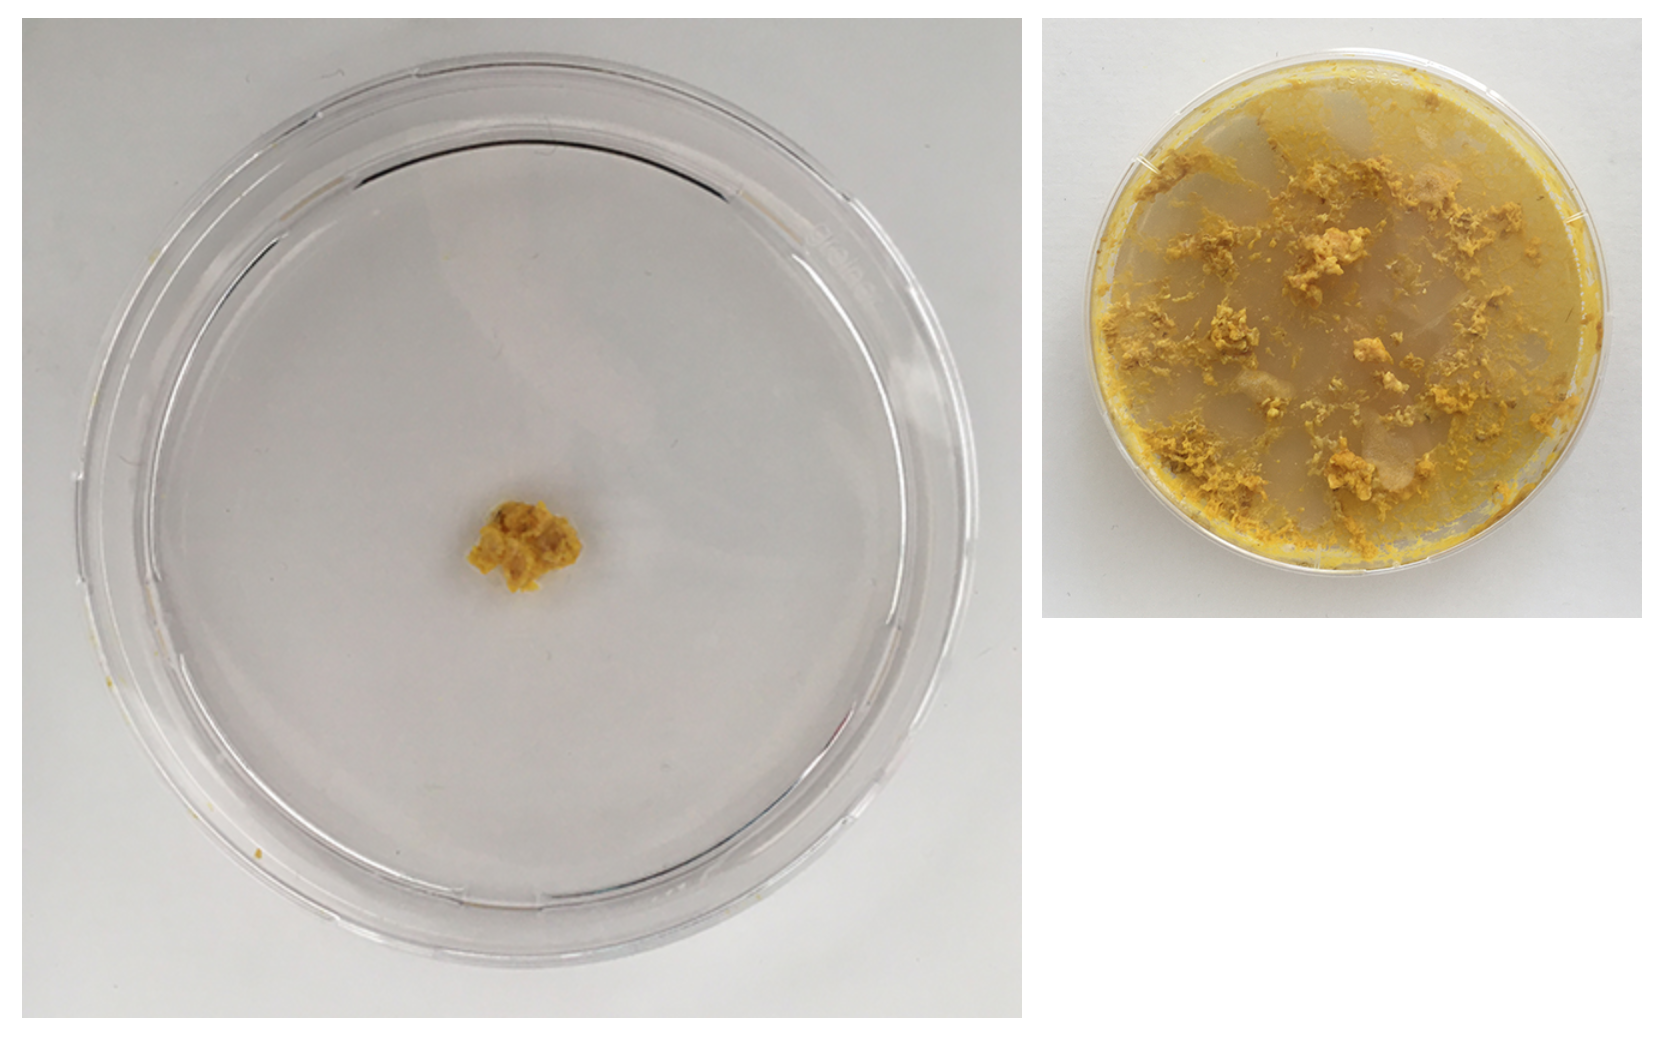
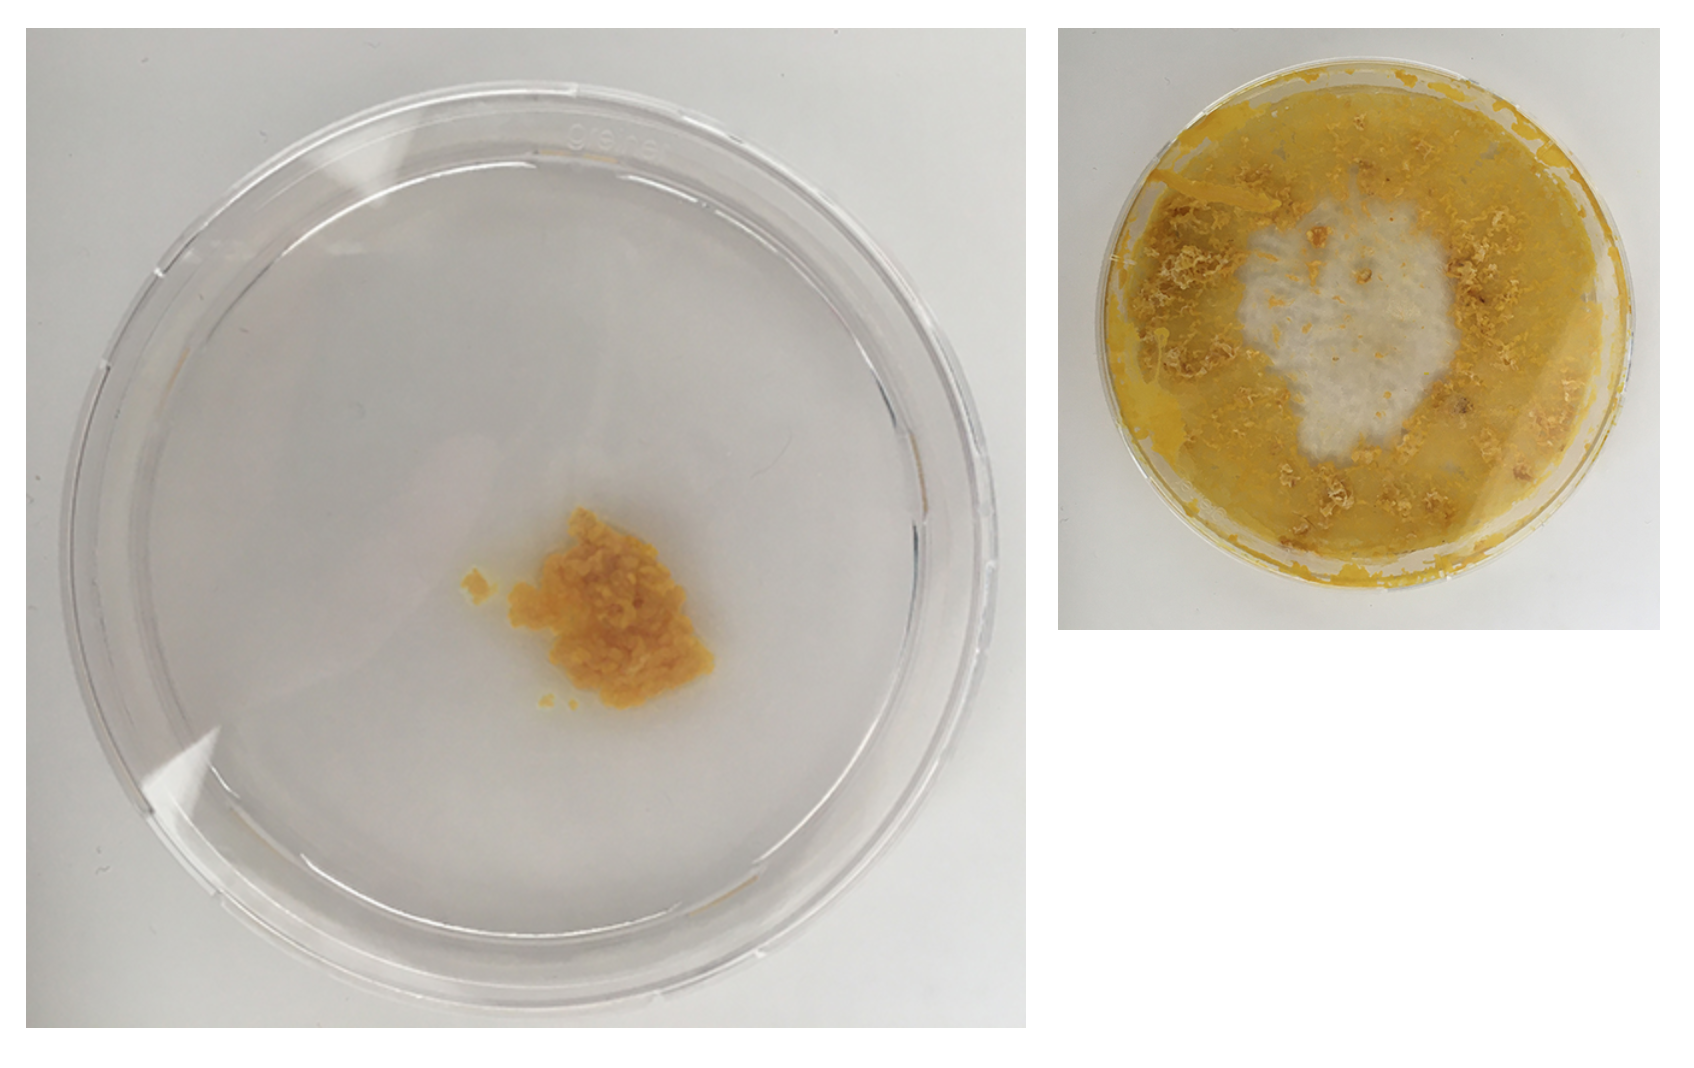
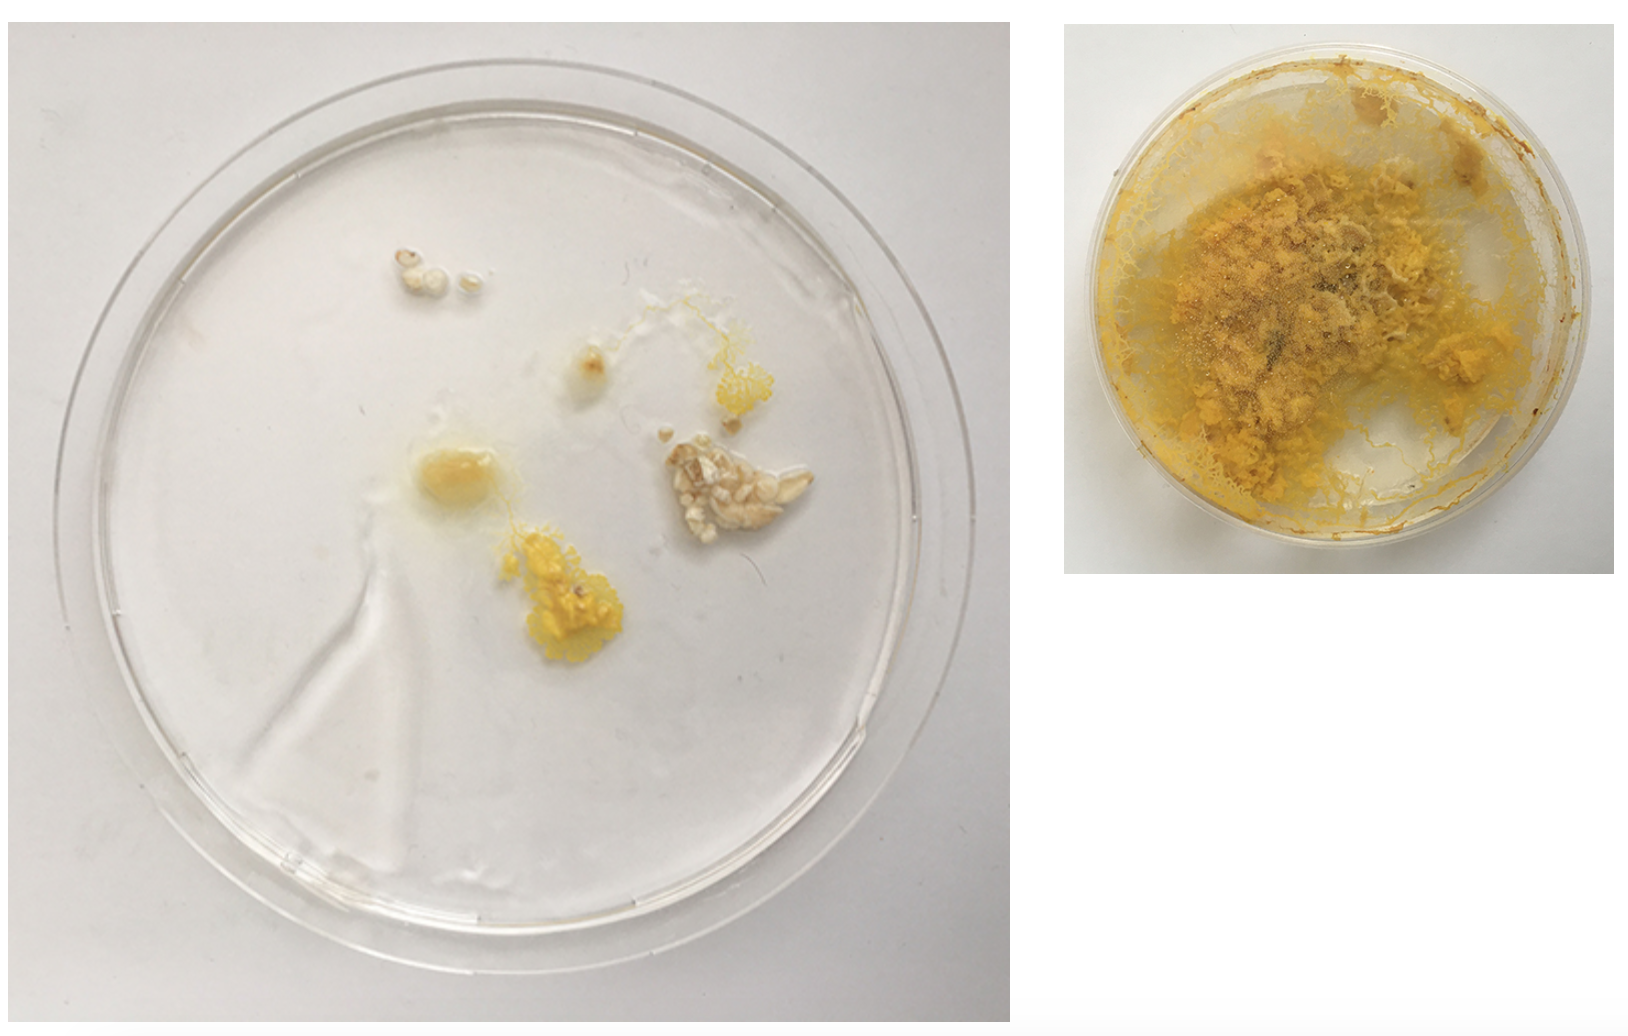
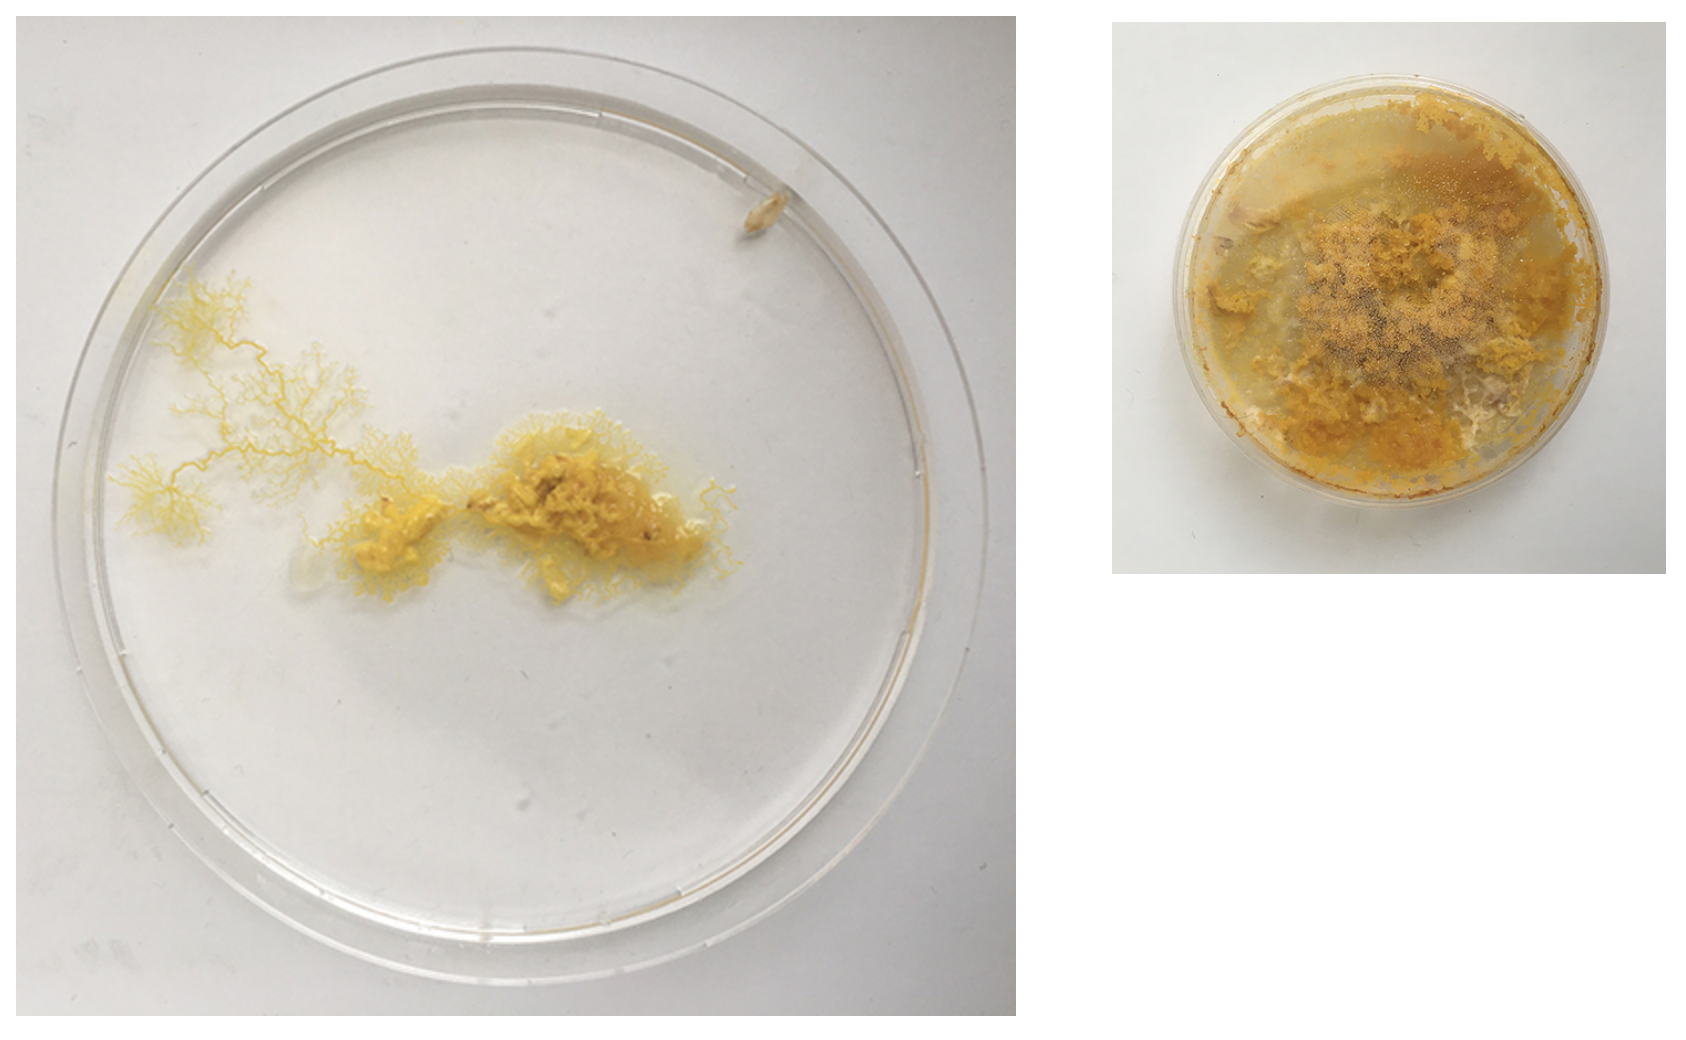
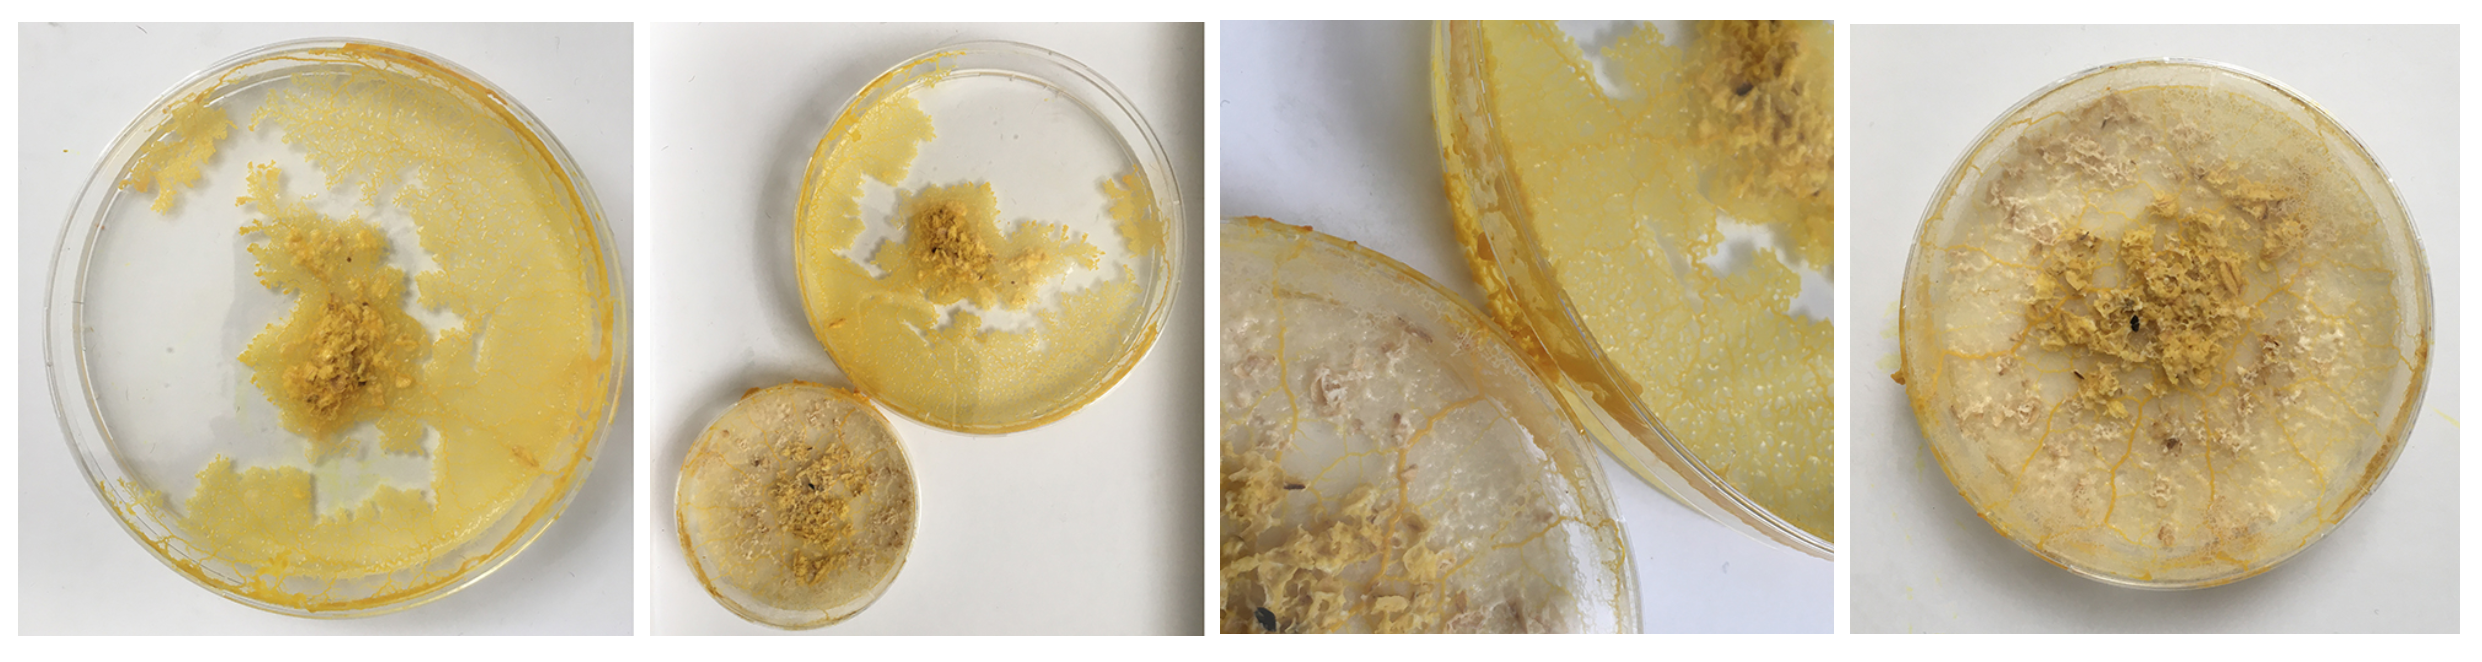

GMU:If the organism will not come to me, I will go to the organism/Kristin Jakubek/Living in captivity picture dairy: Difference between revisions
(No difference)
|
Revision as of 09:31, 8 July 2020
Sun. 31.05 Starting to notice this white-ish slime. First I thought it was mold but now I think it is the trace that Physarum leaves behind itself - which if it has enough space hinders it from going to this spot again. Might be having a strange reaction with the Agar?
Sun. 31.05 Seeing an answer to the question: does physarum grow on surfaces that are not Agar: yes! Does it maybe draw the moisture from the surface of agar so that it doesn't need it in other/all areas?
Also you can start to see the digested oats that are no longer yellow so the blob moved off of them because they offer no more for it.
Sat. 30.05 - decided to 'feed' some less to start seeing a difference in behaviour
Sun. 31.05 - because I don't want to much moisture to build up (might lead to bacterial mold) and to keep caring well for the Physarum & first get a better understanding of it, I gave each dish a full spoon of oats today.
The Physarum's structure is obviously much better visible when NOT ON OATS - so what are aesthetic and sustainable ways to replace the oats or make the food source disappear?
Mon. 01.06 - The first petri-dish, probably older than a week now changed colors, it doesn't look like mold but it's clearly much much darker then if was yesterday. Also doesn't look like the other phases of the life cycle?
Mon. 01.06 - Also there is a lot more moisture in the dishes again - maybe today is finally a day to inoculate? Clearly 6 days is the limit - better to change them after 5 days - like this guide also suggests: https://drive.google.com/drive/folders/1BYdpvPxnUNgdqqu1ELHTnbWlc0cQqvu6
Mon. 01.06 - Here you can see Physarum build a squiggly mass on top of the oats, it's more like a pile of yellow little blobs than the vein like structure.
Mon. 01.06 - Also other dishes are starting to form black dots which I can see more clearly from the bottom - which show bacterial/Yeast contamination and indicate that I should change the dish. Clearly the Physarum wants out, but isen't even healthy enough to make it.
A new inoculation follows!
What isen't really clear to me is what to do with the old dishes from which I inoculate new ones? Do I let them go their course? Do I try to transfer as much of the blob and then let the leftovers dry?
Answer - Mon. 08.06: I wait until the dish is fully dried out our possibly contaminated to throw away whole dish in worst case or clean out the already dried Physarum. I now have pre-made petri-dishes for when a lot tries to escape. If only a little tries to come out I put it back in the same dish.
Observational notes
1 large petri dish the agar never settled even though it is the same mix as the others- possible because I moved it too soon disrupting the cooling process?
Also I need to make sure I have a bit more Agar next time as the solution is very wet in general.
The petri-dishes with the discarded oats and Physarum clearly show that Physarum senses no more food and is trying quickly to escape to survive somewhere else.
Also the medium older dishes show me that Physarum has a sense for the environment and tells me very clearly it wants a new home! Even with enough food it wants to move on somewhere with better conditions - within one night it's climbed half way out the lid. The others are quite happy where they are though.
The small dishes - after I removed the excess /old food seem 'happy' - they've reconnected and are staying inside the dish, also no colour change but the structure looks like it might be going towards spores.
I'm getting a sense for how Physarum perceives it's environment slowly.
Day 1 - freshly transplanted
I removed the oats with Physarum from the old dishes and preserved it.
Day 2 - still strong but also fast moving out of the dish. clear indicator that the leftovers can't just be thrown away as the organism still lives on even when perceived as 'discarded' by me. Even spreading faster than on the new Agar dishes.
Day 3 - The structure already looks much weaker and the colour is more faint
Day 1 - First movements in the big dishes
All small dishes are starting to look 'healthier' again - strong structure and colouring
I had these liquidy membrane looking blob parts - what are they? A weird form from the Agar which was too liquid? Answer: When compared to the freshly inoculated dish: these are the spots of the Physarum placed - it moved from this spot quickly on to the fresh oats and these spots might have had a strange reaction with the still too fresh Agar or brought rests that where no longer good for Physarum and turn into this weird blob.
Here, in both dishes, we can see the dish looks quite dry - in the one on the left the Physarum is crawling out because the environment is not good enough anymore.
In comparison the new dishes have a very moist agar (too moist) and are spreading out across the space.